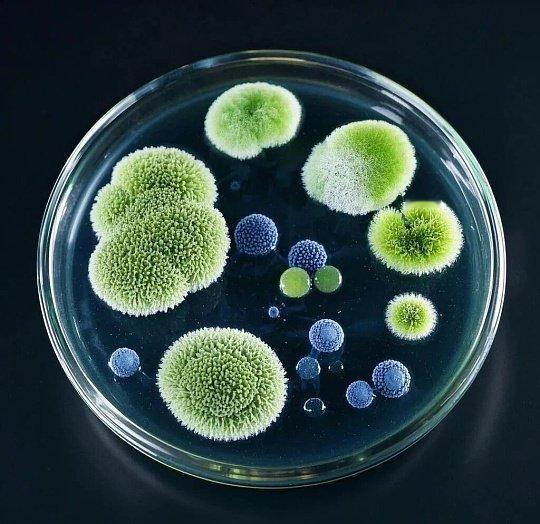

浴室除霉菌 霉菌视角我无处不在,瓷砖缝隙、玻璃胶边、浴帘角落都是我的家。浴室常年潮湿闷热,就是我繁衍的温床。肉眼看不见我的时候,我早已遍布各处,散发异味、侵蚀墙面,悄悄引发过敏长痘、咳嗽不适。清水擦不掉我,普通清洁剂也困不住我。只要你洗完澡不擦干积水、不及时通风,我就会越长越多。想要彻底消灭我,断绝潮湿环境、深度强效除霉,我才会彻底消失。



浴室除霉菌 霉菌视角我无处不在,瓷砖缝隙、玻璃胶边、浴帘角落都是我的家。浴室常年潮湿闷热,就是我繁衍的温床。肉眼看不见我的时候,我早已遍布各处,散发异味、侵蚀墙面,悄悄引发过敏长痘、咳嗽不适。清水擦不掉我,普通清洁剂也困不住我。只要你洗完澡不擦干积水、不及时通风,我就会越长越多。想要彻底消灭我,断绝潮湿环境、深度强效除霉,我才会彻底消失。

作者最新文章
热门分类
娱乐TOP
娱乐最新文章